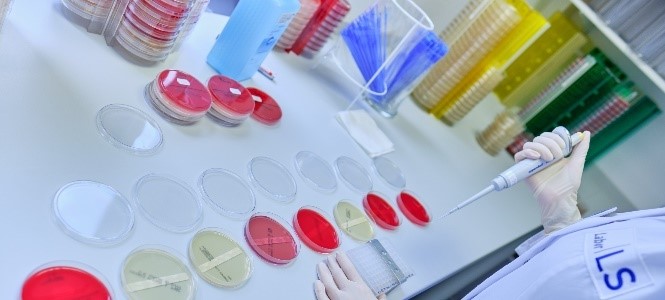

Blog
Corona-Monitoring
Corona-Monitoring als wichtiger Bestandteil Ihres Personalhygiene-Konzeptes. Die letzten Monate haben Ihnen sicher ebenso wie uns viel abverlangt. Die zahlreichen zusätzlich implementierten Hygieneregeln erforderten eine Vielzahl von Prozessanpassungen. Speziell die Änderungen der individuellen Verhaltensregeln sowie das Ausbleiben der zahlreichen internen und externen Kundenbesuche änderten Ihren und unseren Geschäftsalltag eindrücklich. Es gibt aber auch eine gute Nachricht für Sie:
Wir sind sehr froh darüber, dass wir Ihnen unsere Dienstleistungen auch weiterhin in gewohnter Qualität, auf weiterhin hohem Servicelevel und zu stabilen Preisen anbieten können.
Wir haben die letzten Wochen sogar dazu nutzen können, unser betriebshygienisches Leistungsspektrum sinnvoll um Corona-Tests für Ihre Mitarbeiter*innen zu erweitern. Gerne untersuchen wir für Sie in unserem medizinischen Ressort „Enterosan®“ von Ihrem/r Betriebsarzt/ärztin entnommene HNO-Abstriche molekularbiologisch auf SARS-CoV-2 und detektieren damit akute Infektionen bzw. potenzielle Virusausscheider. Darüber hinaus testen wir gerne auch Blutproben auf spezifische SARS-CoV-2-IgG-Antikörper. Diese weisen auf überstandene Infektionen und damit auf eine vermutlich bestehende Immunität hin.
Für Sie als Unternehmen sind präventive Corona-Maßnahmen ebenso wichtig wie für uns. Sie haben daher sicher ein starkes Interesse daran, den Gesundheitszustand Ihrer Mitarbeiter*innen aufmerksam zu monitoren. Das bringt für Sie als Unternehmen zusätzliche Prozesssicherheit.
Sehr gerne erstellen wir Ihnen für die systematische Testung Ihrer Mitarbeiter*innen ein individuelles Angebot. Haben Sie noch Fragen? Dann stehen wir Ihnen sehr gerne Rede und Antwort.
Kontaktieren Sie uns
|
Labor LS SE & Co. KG Mangelsfeld 4, 5, 6 97708 Bad Bocklet-Grossenbrach |
Ansprechpartner Thomas Meindl Sales & Services |
Es freut uns, wenn Sie diesen Blogbeitrag kommentieren. Kommentar erfassen 141 Gefällt mir 447














































































































































